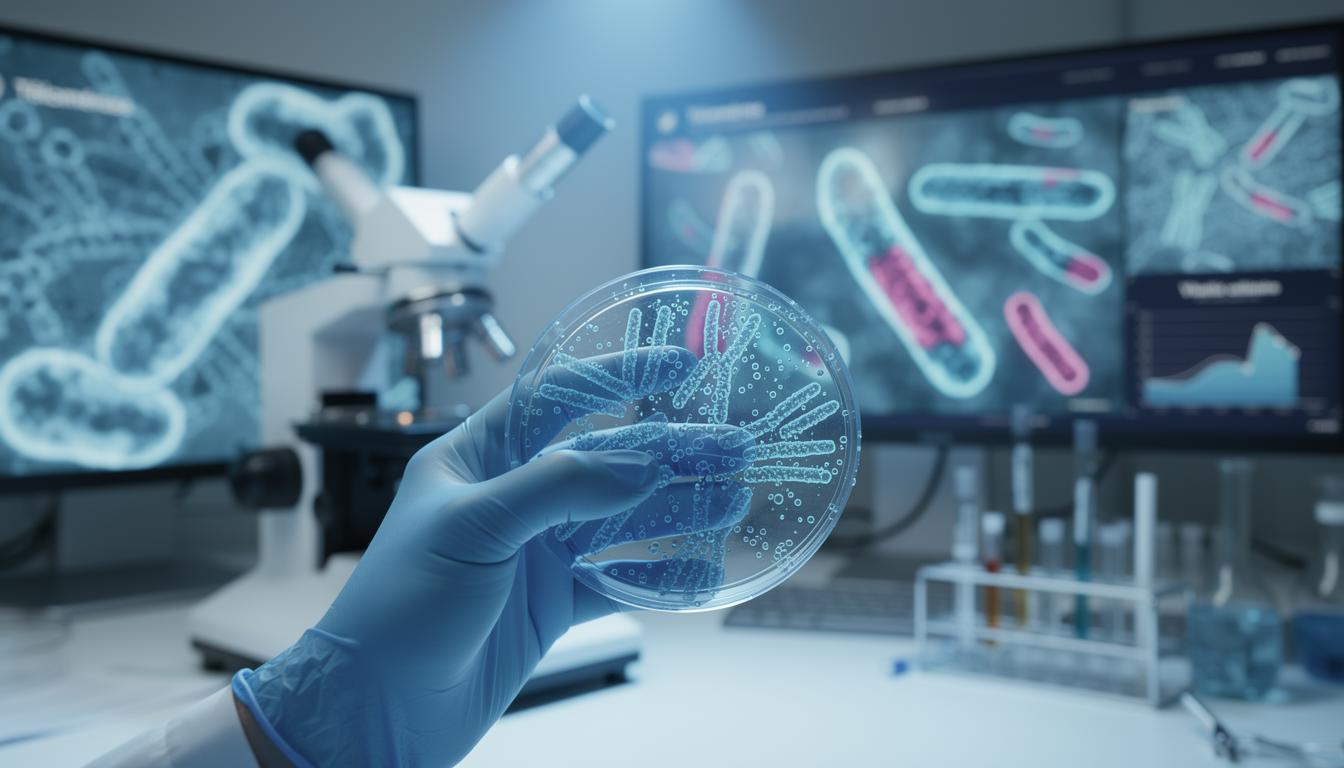

Consulting spécialisé en santé et bien-être
Chez Sante Balance, notre objectif est de favoriser une vie équilibrée et saine pour tous.
Expertise en nutrition et santé mentale
Chez Sante Balance, nous croyons en l’importance d’une alimentation saine et d’un esprit sain pour un corps équilibré.
Bienvenue sur Sante balance:
Notre site est dédié à fournir des informations fiables sur le bien-être, la nutrition, la forme physique et la santé mentale. Le but de sante-balance.fr est d’autonomiser les individus à prendre des décisions éclairées sur leur bien-être, favorisant une vie équilibrée et saine.
Empower Yourself with Our Comprehensive Health Articles
At Sante balance, our mission is to provide individuals with the resources, knowledge and confidence to make informed decisions about their well-being.
Nos Services
Consulting
Nous offrons une approche holistique pour la santé en proposant des services couvrant tous les aspects du bien-être.
Nutrition Équilibrée
Découvrez comment une alimentation équilibrée peut améliorer votre santé générale et votre style de vie.
Activité Physique
Rejoignez-nous pour apprendre les dernières tendances et conseils en matière de fitness pour un corps sain et fort.
Sante balance – Votre source fiable d’informations sur la santé et le bien-être
Offrir une expertise de consultation pour une meilleure santé et un bien-être optimal
Chez Sante balance, nous sommes dévoués à fournir des informations précises et fiables sur la santé et le bien-être. Que vous cherchiez des conseils d’experts, des tendances actuelles ou des astuces pratiques pour améliorer votre mode de vie, nos articles complets répondent à tous les aspects de la santé.
Prêt à prendre le contrôle de votre santé et de votre bien-être?
Articles récents
Découvrez les derniers articles de notre blog pour rester informé sur les tendances et conseils en matière de bien-être.
La télomérase : un enjeu majeur pour la longévité cellulaire en 2026
Vous parcourez la frontière ténue entre sciences et promesses depuis que la télomérase, silencieuse mais puissante, s’impose comme un[…]

Les bienfaits surprenants de l’huile essentielle de lavandin
L’huile essentielle de lavandin sur lavandes.fr révèle des propriétés exceptionnelles pour la relaxation profonde et le bien-être quotidien. Reconnue[…]

Médecine holistique : votre chemin vers l’équilibre personnel
La médecine holistique considère l’être humain dans sa globalité corps-esprit-âme, dépassant les symptômes pour traiter les causes profondes des déséquilibres.[…]

Acheter du cbd au kg : guide pour les professionnels
Le marché français du CBD connaît une croissance remarquable avec un chiffre d’affaires estimé à 400 millions d’euros en 2024[…]

La crème visage fille : votre alliée pour une peau parfaite
Une crème pour le visage adaptée aux jeunes filles : l’essentiel à savoir La peau des adolescentes traverse des[…]

Plug anal : tout comprendre sur un jouet sexuel dédié au plaisir anal
Dans de nombreux échanges entre partenaires ou lors d’une recherche en boutique spécialisée, une question revient souvent : comment[…]

Gummies intimes : soutien moderne pour la santé féminine et l’équilibre intime
De nombreuses femmes cherchent aujourd’hui des solutions innovantes pour préserver leur bien-être intime au quotidien. Parmi ces nouveaux alliés,[…]

Nouvelle méthode pour arrêter de fumer à genève : réussissez avec l’hypnose
Une nouvelle méthode pour arrêter de fumer à Genève : l’hypnose thérapeutique L’hypnose thérapeutique émerge comme une alternative efficace[…]

Hydrojet dentaire : votre allié pour des dents éclatantes
L’hydrojet dentaire élimine 99,9% des bactéries dans les zones difficiles d’accès, selon une étude clinique publiée dans le Journal of[…]

Magasins de chanvre pas cher : qualité et économies garanties !
Le marché français du CBD affiche une croissance exceptionnelle de +45% en 2025 selon FranceAgriMer, démocratisant l’accès à ces produits[…]

Comprendre la tolérance au CBD : comment optimiser ses effets
Le cannabidiol séduit par ses propriétés relaxantes, anti-inflammatoires et anxiolytiques. Selon une étude de l’ANSM, 12% des Français utilisent désormais[…]
Transformez la vie des seniors : l”impact des cours de langue des signes sur leur communication et leur quotidien
Introduction aux cours de langue des signes pour les seniors La langue des signes est un outil de communication[…]
Tricot, sérénité et seniors : les meilleures techniques de relaxation pour diminuer le stress
Techniques de relaxation adaptées aux seniors Le bien-être des seniors peut être grandement amélioré par diverses techniques de relaxation.[…]
Aromathérapie pour les seniors : 5 approches novatrices pour renforcer le moral et réduire l”anxiété.
Approche 1 : Utilisation des huiles essentielles spécifiques L’aromathérapie seniors utilise des huiles essentielles pour améliorer le bien-être émotionnel.[…]
Bien comprendre et vivre avec les acouphènes
Comprendre les acouphènes Les acouphènes sont une perception auditive qui n’est pas générée par une source sonore externe identifiable.[…]
Boostez votre Concentration et Vigilance : Les Secrets du Thé Matcha
Les Propriétés du Thé Matcha Le thé matcha possède une composition nutritionnelle exceptionnelle, notamment grâce à ses riches propriétés[…]
Tout ce qu’il faut savoir sur la vie sexuelle durant la grossesse : guide essentiel
Comprendre les changements physiologiques durant la grossesse Pendant la grossesse, le corps de la femme subit de nombreux changements[…]
Améliorer l”accompagnement des patients avec troubles gastro-intestinaux : stratégies efficaces à mettre en œuvre !
Comprendre les troubles gastro-intestinaux Les troubles gastro-intestinaux peuvent prendre de nombreuses formes, allant des maux d’estomac fréquents aux syndromes[…]
Approches créatives et efficaces pour les experts de la santé dans l”évaluation de la violence chez les adolescents.
Compréhension de la violence chez les adolescents Comprendre la dynamique de la violence chez les adolescents nécessite une exploration[…]
Améliorer le suivi des patients atteints de maladies auto-immunes : tactiques efficaces pour les professionnels de la santé
Stratégies pour améliorer le suivi des patients L’amélioration du suivi des patients repose sur des stratégies bien définies qui[…]
Astuces Fitness Grossesse : Tout Savoir pour Rester Mince et en Forme
Importance de la fitness pendant la grossesse Pendant la grossesse, maintenir une forme physique peut avoir des bénéfices considérables[…]











